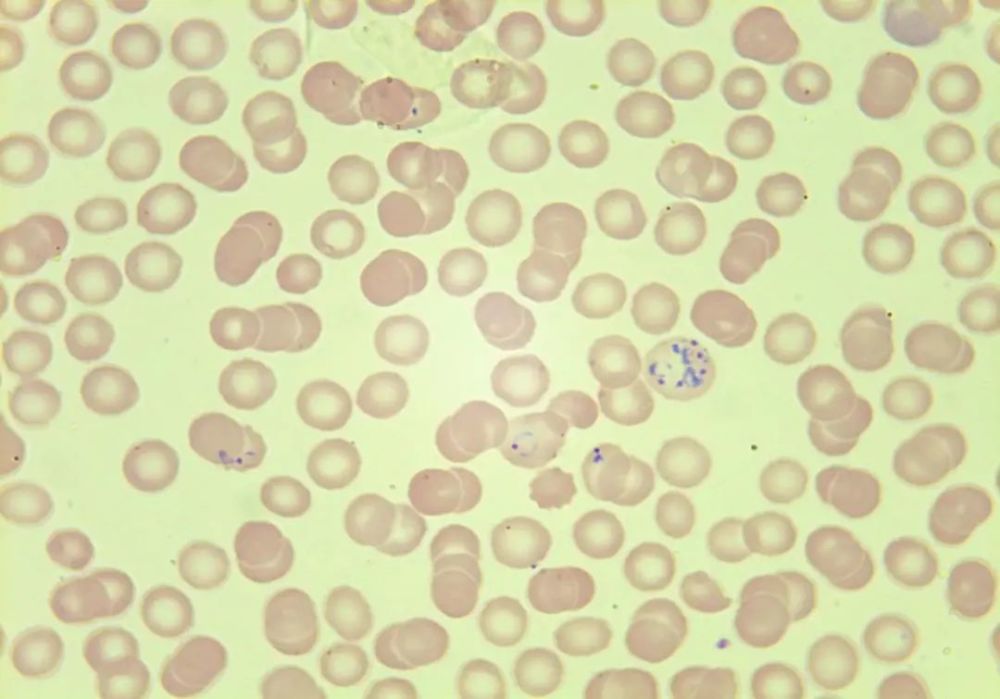
图为疟原虫环状体,滋养体 提示疟疾   part 白细胞形态给我们的反馈

恶性疟原虫环状体

人红细胞中处于环状期的恶性疟原虫.
图片尺寸640x426
有一种难过叫,我不在这里 ——君安精选案例"散点话疟疾"_疟原虫
图片尺寸1080x720
单环双核,双环双核(瑞士-吉姆萨染色)多个较小疟原虫环状体寄生同一红
图片尺寸1117x726
这幅图片展示了红细胞,其中一些被环状体阶段的疟原虫感染.
图片尺寸600x554
求疟原虫图片
图片尺寸4370x1670
恶性疟原虫各个时期形态(图片来源:https://wenku.baidu.
图片尺寸254x339
外周血涂片:典型恶性疟原虫 1 例
图片尺寸640x664疟原虫疟疾环状状态
图片尺寸1200x800大滋养体,裂殖体,配子体)恶性疟原虫(环状体,配子体)
图片尺寸1080x1439
疟原虫具有抗药性 e.
图片尺寸281x696
疟原虫切片(环状体和滋养体)_哔哩哔哩 (゜-゜)つロ 干杯~-bilibili
图片尺寸1086x610
恶性疟原虫的介绍
图片尺寸1337x747
恶性疟原虫环状体记了但什么都没记上的实验记录
图片尺寸1762x2048
四种疟原虫镜下图(1)ppt
图片尺寸1080x810
人体疟原虫镜检技ppt
图片尺寸1080x810
恶性疟原虫环状体▼间日疟原虫雄配子体▼间日疟原虫雄配子体▼间日
图片尺寸1080x892
间日疟原虫,卵形疟原虫,三日疟原虫和恶性疟原虫
图片尺寸466x262
图为疟原虫环状体,滋养体 提示疟疾 part 白细胞形态给我们的反馈
图片尺寸1000x699
疟原虫形态恶性疟
图片尺寸960x720
恶性疟原虫环状体▼间日疟原虫雄配子体▼间日疟原虫雄配子体▼间日
图片尺寸1080x1079
猜你喜欢:恶性疟原虫配子体手绘间日疟原虫雄配子体疟原虫配子体恶性疟原虫恶性疟原虫配子体间日疟原虫配子体恶性疟原虫四个时期图疟原虫环状体手绘图环状体恶性疟原虫各期手绘图间日疟原虫成熟裂殖体疟原虫环状体间日疟原虫滋养体恶性疟原虫滋养体间日疟原虫雌配子体间日疟原虫间日疟原虫四个时期图间日疟原虫环状体间日疟原虫雌雄配子体恶性疟原虫图片间日疟原虫裂殖体恶性疟原虫环状体结构恶性疟原虫环状体绘图恶性疟原虫环状体手绘恶性疟原虫裂殖体疟原虫环状体手绘恶性疟原虫雄配子体恶性疟原虫雌雄配子体恶性疟原虫雌配子体间日疟原虫环状体绘图涟源市三一学校上海雷允上大药房总店小舍得宋佳头发团拜会横幅标语虞姬素描圆锥斜切展开图真正拉菲酒图片张学友吃食啦你小区里内衣地道战电影五得利六星面粉羊城交通台 路文文